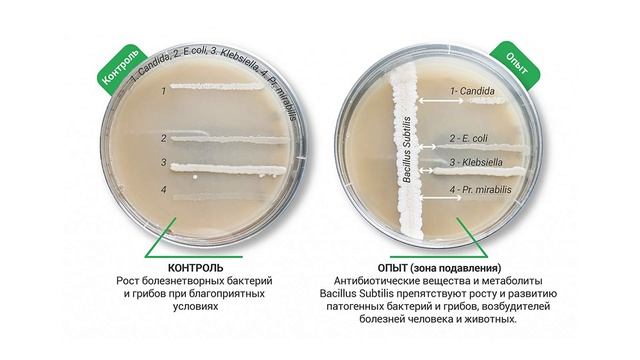
Защита растений в дождливую погоду смотреть онлайн

Автор / Канал: Зоопарк аквариум Страница 14

Butch Cassidy and the Sundance Kid (1969) - Film Review

第249話CAFE IBIS

soulmates placebo cover

Лісовий полоз (неотруйна змія)
Защита растений в дождливую погоду

EMU 365 Series: Arun Sayal on evaluating pediatric elbow injuries

Локохроника №5. Локомотив - Урал 23 ноября 2018

laska je laska (feat. eri)

Кит ворвался в папг!👹👹👹#pubgmobile #pubg #кит#Bronk-pupg

Rammstein- Sonne (Live in Los Angeles, CA) (Sept 23, 2022)

черепашки ниндзя 2 сезон 20 серия кто такая эйприл онил часть 1

Pendulum Tarantula

Когда звери мечтают 2014
![[Katya Series] Playing Engklek смотреть онлайн [Katya Series] Playing Engklek смотреть онлайн](https://pic.rtbcdn.ru/video/2025-02-03/f2/81/f2811263e4ad87a828ed40a3fb07e9c4.jpg)
[Katya Series] Playing Engklek

Bustling animal world sounds, monkey, gorilla, flamingo, lion, tiger, koala bear, panda

Golaço de Voleio - FC 24 PlayStation 5

Сингапурские хомяки

Let's Play По Minecraft Часть 1(1)

475 королевство доказательства нападения CVC 27-28 июня 2018

Gotta take that call🙄📲 |roblox edit|

Кормим сушенными лапками

Разбор Рынка,ХАЙП который мы заслужили

Готовлю вкусняшки для внучки. Отвезла дочь с зятем в аэропорт.

Eyvaz Rzayev
За каждым успешным каналом стоит личность, идея и сотни часов кропотливого труда. Если вы здесь, значит, автор «Зоопарк аквариум» уже сумел зацепить ваше внимание своим уникальным стилем или подачей. А мы на RUVIDEO позаботились о том, чтобы вы могли изучить весь архив его работ в максимально комфортных условиях — без лишней суеты и преград.
Почему за работами канала «Зоопарк аквариум» так интересно наблюдать? Всё просто: это честный контент, который находит отклик в сердцах зрителей. На нашем ресурсе вы можете смотреть онлайн все видео любимого автора бесплатно и в хорошем качестве. Нам важно, чтобы вы видели каждую деталь и слышали каждый нюанс, поэтому мы используем только стабильные плееры из открытых источников Rutube.
Следите за новинками канала, пересматривайте старые шедевры и открывайте для себя новые грани творчества «Зоопарк аквариум». Мы постоянно обновляем ленту, чтобы у вас под рукой всегда были самые свежие выпуски. Никаких сложных регистраций — только вы и творчество, которое вдохновляет. Приятного вам путешествия по миру авторского контента на RUVIDEO!
Видео взято из открытых источников Rutube. Если вы правообладатель, обратитесь к первоисточнику.